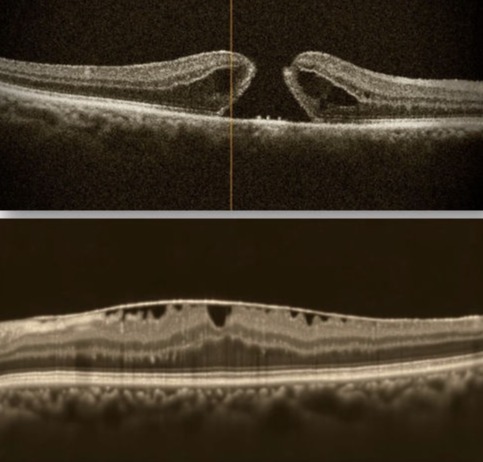
Mobirise

Makula deliği (üstte) ve epiretinal membran (altta)
OKT görüntüleri
Makula Cerrahisi
Makula retinanın merkezinde yer alan renkli ve keskin görmeyi sağlayan özelleşmiş bir bölgedir. Makula cerrahisi "vitrektomi" ameliyatıyla makula bölgesinde yapılan tamiri ifade eder. Sıklıkla “makula deliği” ve “epiretinal membran” nedeniyle uygulanır.
Makula deliği; makulanın merkezinde oluşan delinmedir. Sıklıkla yaşlanmayla kendiliğinden ortaya çıkan bir durumdur, ancak yüksek miyopi, göz travmaları nedeniyle ya da tekrarlayan üveit gibi durumlarda da oluşabilir. Makula deliği sıklıkla tek gözde tespit edilmekle birlikte, eğer bir gözde oluştuysa diğer gözde oluşma riski artar. Retina muayenesinde kolaylıkla tespit edilmekle birlikte optik koherens tomografi (OKT) ile tanı teyit edilerek, deliğin büyüklüğü ve cerrahi tedaviden faydalanma ihtimali daha hassas bir şekilde değerlendirilebilir. Deliğin oluşmaya başladığı erken dönemde bulanık görme, düz çizgilerde bükülme, dalgalanma gibi şikayetler olurken, tam kat deliğin oluşmasıyla görme azalır ve merkezi görme kaybı oluşur. Bu durum hastalar tarafından genellikle bakılan yerin tam ortasında gri-siyah bir kör nokta ya da karanlık alan olarak tarif edilir. Vitrektomi ameliyatı ile delik tamiri ve göz içine gaz injeksiyonu en çok uygulanan cerrahi yaklaşımdır.
Epiretinal membran (ERM); retinanın iç yüzeyinde zar oluşumudur. ERM sıklıkla yaşlanmayla ortay çıkan bir durumdur, ancak retinal yırtık ve dekolmanlar, diyabetik retinopati, retinal ven tıkanıklıkları, travmalar, retina lazer uygulamaları ve tekrarlayan üveitler de neden olabilir. Sıklıkla erken dönemde hasta tarafından bir şikayete neden olmaz ancak, muayeneyle özellikle OKT tetkikiyle kolaylıkla tespit edilebilir. Hastalığın ilerlemesiyle görüntüde eğilme, dalgalanma gibi yakınmalara ilave olarak ağrısız görme kaybı oluşur. Vitrektomi ameliyatıyla ERM soyularak tedavi sağlanır.
Vitrektomi ameliyatından sonra katarakt gelişmesi beklenen bir durumdur. Makula cerrahisi uygulanan hastaların çoğunlukla ileri yaşlarda oldukları dikkate alındığında, vitrektomi ameliyatının katarakt cerrahisiyle birlikte uygulanması sıklıkla tercih edilen bir yaklaşım olmaktadır.
